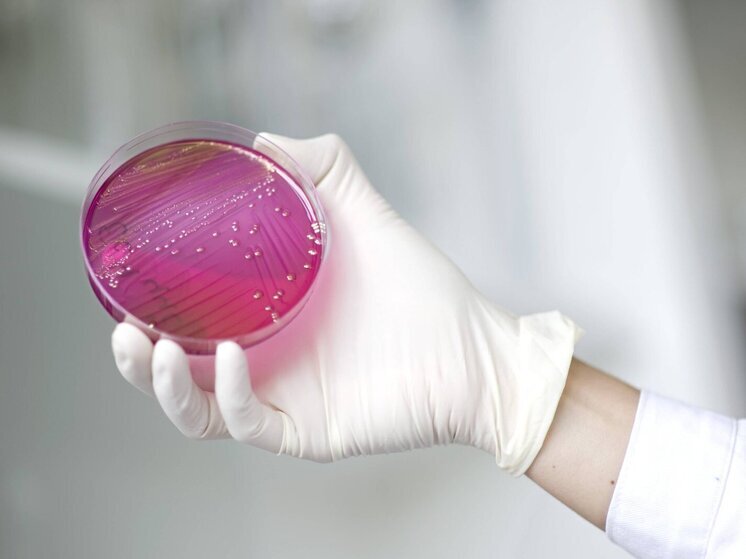
Уголовное дело возбуждено по факту отравления на танцевальных соревнованиях в Люберцах

Управление Роспотребнадзора по Московской области начало эпидемиологическое расследование в связи с случаями заболевания острой кишечной инфекцией в Люберцах, сообщает ведомство в своем телеграм-канале.
По предварительным данным, заболевшие участвовали в соревнованиях по бальным танцам и употребляли пищу, предоставленную кейтеринговой компанией, с которой заключил договор организатор мероприятия. Доставка еды осуществлялась из другого региона России. В настоящее время Роспотребнадзор проводит комплекс противоэпидемических мероприятий, и ситуация находится под контролем ведомства.
В Следственном комитете РФ подтвердили, что по факту отравления возбуждено уголовное дело по статье 238 УК РФ (оказание услуг, не отвечающих требованиям безопасности). Глава СК поручил руководителю ГСУ СК России по Московской области представить доклад о ходе расследования, и исполнение этого поручения взято на контроль в центральном аппарате.